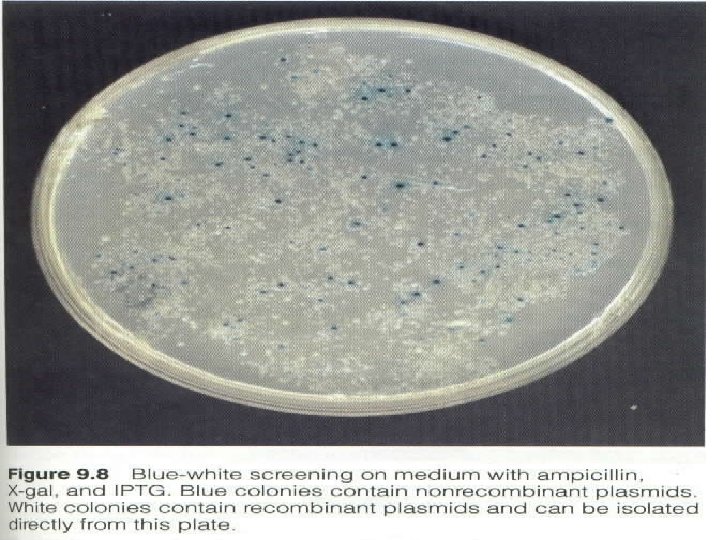

VBC321 Animal Biotechnology Gene Cloning Gene Cloning Requirement

VBC-321 Animal Biotechnology Gene Cloning

Gene Cloning

Requirement for Gene Cloning • • Enzymes Insert DNA Vector Host cell

Enzymes used in gene cloning • Restriction endonuclease- cut the DNA at Specific site, these of often known as molecular scissor • DNA ligase- joining of two DNA molecule, often known as molecular glue • Reverse transcriptase- use to produce c. DNA from m. RNA • Alkaline phosphatase- for removing 5’ phosphorus from DNA ends. • T 4 Polynucleotide kinase- for addition of phosphate group to an end having a free 5’- OH

• S 1 nuclease- for removal of single stranded protrusions from ends, both 3’ and 5’ protrusion are removed • Klenow fragment of E. coli DNA polymerase I- to make the protruding ends double stranded by extending the shorter strands • Lambda Exonuclease- for removal of nucleotide from 5’ ends • Exonuclease III- for removal of nucleotides from 3’ end • Terminal deoxynucleotidyl transferase- for addition of single stranded sequence to 3’ end of blunt ended fragment

Bacterial transformation • Transformation is processes by which exogenous genetic material may be introduced into a bacterial cell Methods Chemical method Electroporation

CHEMICAL TRANSFORMATION WITH CALCIUM CHLORIDE

TRANSFORMATION BY ELECTROPORATION

TRANSFECTION • Transfection is the process of introducing nucleic acids into eukaryotic cells by using carrier molecules • Animal cells are transfected by opening transient pores or holes in the cell membrane to allow the uptake of material • Genetic material such as plasmid DNA or si. RNA constructs or proteins such as antibodies may be transfected into cells • Transfection may cause changes in morphology of target cells

METHODS Calcium Phophate method : • One of the cheapest methods of transfection is by calcium phosphate. • HEPES-buffered saline solution containing phosphate ions is combined with a calcium chloride solution containing the DNA to be transfected • Mixing of these two results in precipitate due to binding of positively charged calcium and the negatively charged phosphate • This suspension of precipitate is then added to the cells to be transfected, usually a cell culture grown in a monolayer • The cells take up some of the precipitate and the DNA

• Liposome method : • It is a very efficient method of transfection. Liposomes, a small, membrane-bounded body that are in similar to the structure of a cell and can actually fuse with the cell membrane • The DNA to be transfected is trapped into the liposomes • This DNA loaded liposome is added to the cells to be transfected and release the DNA into the cell

PLASMID CLONING STRATEGY • Involves five steps: Enzyme restriction digest of DNA sample. Enzyme restriction digest of DNA plasmid vector. Ligation of DNA sample products and plasmid vector. Transformation with the ligation products. Growth on agar plates with selection for antibiotic resistance.

STEP 1. RE DIGESTION OF DNA SAMPLE

STEP 2. RE DIGESTION OF PLASMID DNA

STEP 3. LIGATION OF DNA SAMPLE AND PLASMID DNA

STEP 4. TRANSFORMATION OF LIGATION PRODUCTS • The process of transferring exogenous DNA into cells is call “transformation” • There are basically two general methods for transforming bacteria. The first is a chemical method utilizing Ca. Cl 2 and heat shock to promote DNA entry into cells. • A second method is called electroporation based on a short pulse of electric charge to facilitate DNA uptake.

STEP 5. GROWTH ON AGAR PLATES

STEP 5 • Blue colonies represent Ampicillin-resistant bacteria that contain p. Vector and express a functional alpha fragment from an intact Lac. Z alpha coding sequence. White colonies represent Ampicillin-resistant bacteria that contain p. Insert and do not produce Lac. Z alpha fragment

BLUE/WHITE SCREENING • Colony Selection: finding the rare bacterium with recombinant DNA • Only E. coli cells with resistant plasmids grow on antibiotic medium • Only plasmids with functional lac. Z gene can grow on Xgal lac. Z(+) => blue colonies lac. Z functional => polylinker intact => nothing inserted, no clone lac. Z(-) => white colonies polylinker disrupted => successful insertion & recombination!

α -complementation • The portion of the lac. Z gene encoding the first 146 amino acids (the α -fragment) are on the plasmid • The remainder of the lac. Z gene is found on the chromosome of the host. • If the α -fragment of the lac. Z gene on the plasmid is intact (that is, you have a nonrecombinant plasmid), these two fragments of the lac. Z gene (one on the plasmid and the other on the chromosome) complement each other and will produce a functional β galactosidase enzyme.

SCREENING RECOMBINANTS • In the example shown above, the b-galactosidase gene is inactivated. The substrate "X-gal" turns blue if the gene is intact, ie. makes active enzyme. White colonies in X-gal imply the presence of recombinant DNA in the plasmid.

- Slides: 23